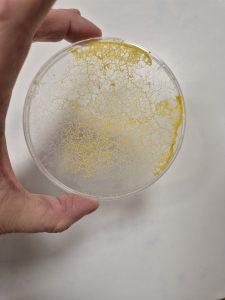
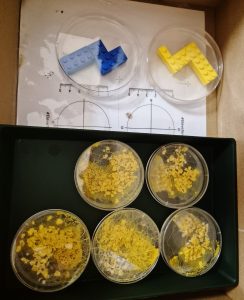

Les élèves de cycle 2 ont accueilli un pensionnaire très particulier : Bloby, envoyé par Audrey Dussautour, chercheuse au CNRS de Toulouse.
Après l’avoir réveillé, ils se sont lancés dans des expériences dignes de vrais scientifiques : labyrinthes en LEGO, choix de nourriture… Bloby a relevé tous les défis avec brio !
Ce projet est aussi l’occasion de rappeler que les sciences sont accessibles à tous, et que les filles, à l’image d’Audrey Dussautour, y ont toute leur place. Dans la classe, chacun devient petit chercheur — et Bloby semble ravi d’être la star de leurs découvertes !